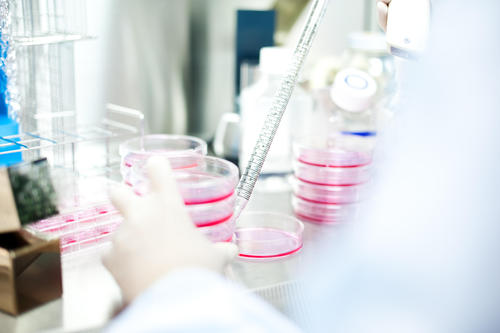
cell_culture_chamber.jpg

2018/07/06(金)
KRPPRESS特集:iPS細胞が拓く未来① 「iPS細胞発表から12年」京都大学 iPS細胞研究所 所長 山中伸弥氏からのメッセージ

その誕生から12年を超え、着実に医療応用に向かうiPS細胞。生みの親である山中伸弥氏からiPS細胞の今、そしてこれからへのメッセージを寄せていただいた。
iPS細胞発表から12年医療応用に向けた取り組み
iPS細胞を使った研究に関するニュースが多数報道されています。その中には患者さんへの移植手術を行うものなどもあり、いよいよ医療として使われる段階に到達したと期待してくださっている方も多いと思います。マウスの細胞を使った研究で、iPS細胞を最初に発表したのが2006年、ヒトのiPS細胞を発表したのが翌年の2007年のことでした。それから10年以上が経過し、iPS細胞技術も進化し、より安全で品質のよいiPS細胞の作製が出来るようになり、着実に医療応用に向けて進んでいます。

iPS細胞技術は大きく分けて、「再生医療」と「創薬研究」で医療応用が進められています。
「再生医療」は、iPS細胞から作った細胞を移植することで、病気やケガなどで失われてしまった細胞の機能を補うものです。最も研究が進んでいるのは加齢黄斑変性という病気を対象とした研究で、iPS細胞から作製した目の網膜の細胞を患者さんに移植し、効果を検討する臨床研究の段階に至っています。この他に、iPS細胞から心臓・神経・角膜・血液などの細胞を作って補う再生医療を目指した研究が進められており、近く臨床研究や治験が開始される予定です。

こうしたiPS細胞を利用した「再生医療」を支える上で欠かせないのが良質なiPS細胞の供給です。京都大学iPS細胞研究所(CiRA)では、「再生医療用iPS細胞ストック」プロジェクトにより、より多くの方に移植可能な細胞の作製・供給を行っています。2018年4月末現在で日本人の約32%に拒絶反応が少なく移植可能な細胞を提供できるようになりました。
「創薬研究」は、患者さんの細胞からiPS細胞を作製し(疾患特異的iPS細胞)、病気が発症する仕組みを調べたり、薬の候補物質を探したり、iPS細胞をツールとして利用する研究です。例えば、FOP(進行性骨化性線維異形成症)という病気の患者さんから作製したiPS細胞を使って、FOPの症状を引き起こす原因を解明し、既存のシロリムスという薬で症状を抑える可能性が見出されました。
昨年夏から、シロリムスの効果を検証する治験が行われています。また、ALS(筋萎縮性側索硬化症)やアルツハイマー病など、様々な疾患で研究が進められています。こうした「創薬研究」を進める上で、疾患特異的iPS細胞を作製し供給することも重要です。CiRAでは既に200種を超える病気の患者さんからiPS細胞を作製し、広く研究で利用できるように理化学研究所バイオリソースセンターに寄託を行っています。この10年ほどで大きく前進したiPS細胞研究ですが、国や民間から多大なご支援をいただき、ここまで辿り着くことができました。
特に2008年度から5年間に渡り科学技術振興機構(JST)の戦略的創造研究推進事業の支援をいただき、京都リサーチパーク(KRP)地区に研究拠点を設置していました。この「山中iPS細胞特別プロジェクト」では、効率よく安全なiPS細胞を作る方法や患者さんから作製したiPS細胞を疾患研究に役立てる方法について研究を行いました。実験設備が整っているKRP地区に速やかに拠点を設置できたことは、世界での競争に遅れることなく研究を進める上で、大変効果的でした。
2009年には、CiRAに「iPS細胞研究基金」を創設し、一般の方から広くご寄付をいただいており、これを用いて優秀な研究者や研究支援者の確保、革新的な研究の支援等、研究環境の充実を図ってまいりました。iPS細胞を使った医療応用の実現を目指し、息の長い研究活動を続けるために、引き続きご支援をお願いできればと考えております。
また、多くの研究仲間にも恵まれました。iPS細胞そのものは基礎的な技術ですが、医療現場での応用を可能とするには実際に現場で患者さんを診ておられる医師、疾患の研究をされている研究者、企業の協力が不可欠です。ヒトiPS細胞を発表した直後から様々な分野の研究者がiPS細胞を利用して新しい治療法の開発に取り組んでくださいました。そして現在のように、様々な疾患に対して成果が出てきており、一部の研究では臨床研究や治験といった段階に達することができたのです。
iPS細胞を用いた医療を多くの患者さんが安心して誰でも使っていただけるようにするためには、まだ解決するべき課題が多数あります。時間はかかりますが、着実に前進し、一日も早く患者さんのもとに届けられるように、これからも頑張ってまいります。
PROFILE

京都大学 iPS 細胞研究所所長 山中伸弥氏
1962 年大阪生まれ、神戸大学医学部卒業後、大阪市立大学大学院医学研究科修了。
アメリカグラッドストーン研究所の研究員や奈良先端科学技術大学院大学の教授などを経て、2006 年に世界で初めてマウスiPS 細胞樹立を報告。
2008 年にiPS 細胞研究センター センター長。
2010 年に京都大学 iPS 細胞研究所 所長。
2012 年にノーベル医学・生理学賞を受賞。
【「KRPPRESS特集:iPS細胞が拓く未来」をもっと読む】
iPS細胞が拓く未来② 「iPS細胞とCiRAについて」 iPS細胞のキホン
iPS細胞が拓く未来③ 「iPS細胞とCiRAについて」 CiRA の活動紹介
iPS細胞が拓く未来④ 「輸血医療 第2のイノベーション」 対談:(株)メガカリオン×KRP(株)
iPS細胞が拓く未来⑤ 「研究開発を加速させるモノづくり企業」CASE1 タカラバイオ(株)
iPS細胞が拓く未来⑥ 「研究開発を加速させるモノづくり企業」CASE2 マイクロニクス(株)
iPS細胞が拓く未来⑦ 「研究開発を加速させるモノづくり企業」CASE3 CORESCOPE(株)
iPS細胞が拓く未来⑧ 「研究開発を加速させるモノづくり企業」CASE4 (株)グローヴ





















